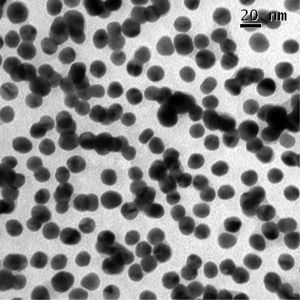
citrateaunp20

Download a printable version of this document here

Nanoparticles are particles that are so small their diameters are on the nanometer scale, that is 10-9 m.
Nanoparticles are interesting to researchers for a number of different reasons. They have a large surface area to volume ratio which means they have a large surface area to take part in chemical interactions – this is an excellent property for catalysts. They can also be designed to clump together in particular ways to give them special properties, this is called self-assembly. They are used in a huge range of applications from medicines, electronics and materials.
Gold nanoparticles have been used since the 4th century for staining glass, although it is unlikely that their nanostructure was known back then! The glass-staining technique can be traced as far back as the roman Lycurgus cup; the glass contains gold nanoparticles which both scatter and absorb light, thus looking red or green from different angles.
Gold nanoparticles are usually suspended as a colloid in a fluid, often water. (A colloid is a system in which there are two phases, with one phase dispersed as tiny droplets on particles with in the other, such as milk). Gold nanoparticles that can be suspended in water are usually made by reducing a gold(III) salt with trisodium citrate, in a method pioneered in the 1950s by the chemist John Turkevich:

The 15 nm gold nanoparticles look like a red solution, and the particles are far too small to see with the naked eye. The particles are stabilised in solution because they are surrounded by citrate anions, and therefore repel each other electrostatically. The colour of the gold nanoparticle solution depends upon the size of the nanoparticles. Gold nanoparticles interact with light in two different way; when the ‘sea’ of free electrons within the metal nanoparticles (the electrons that lead to metallic bonding) are exposed to light, the oscillating electromagnetic field of the light makes these electrons oscillate collectively as the light is absorbed. The particles also scatter light, due to Tyndall scattering. This leads to the 50 nm and 100 nm particles having quite an interesting colour, because the free electrons absorb green light, so they look pink/purple if you hold them up to the light, but they also scatter yellow light quite strongly, so have a yellow-brown ‘glimmer’ to them from a distance. The scattering is less pronounced in the visible range of the spectrum for the 15 nm particles, so they just look red due to the absorption of green light.
The UV-Vis absorption spectra of the 15 nm, 50 nm and 100 nm gold nanoparticles suspended in water is shown below:

The light absorbed by the ‘sea’ of free electrons depends upon the size of the nanoparticle, and gives rise to a peak in the UV-Vis spectrum; you can see that as the particles get bigger the peak shifts to the longer wavelength, i.e. to lower energy. As the peak in the absorption shifts more to the red end of the visible spectrum, the particles solutions look more blue in colour, because we see the light that is not absorbed.
Gold nanoparticles can be imaged by electron microscopy, and can also be imaged under an optical microscope because they scatter light so well.
In the following videos, 15 nm and 100 nm gold nanoparticles are suspended in water, and a laser is passed through the solution. The gold nanoparticles scatter the laser light extremely well, so that we can actually ‘see’ the scattered light from the particles in the solution, under a microscope. The videos clearly show the nanoparticles scattering the light, and you can see the particles moving under Brownian motion in the solution. If you watch carefully, you may be able to see that the smaller particles move faster than the larger particles:
Videos taken using a NanoSight Nanoparticle Tracking Analysis system.
Article written and nanoparticles made and analysed by Nicola Rogers.

This work is licensed under a Creative Commons Attribution 4.0 International License.